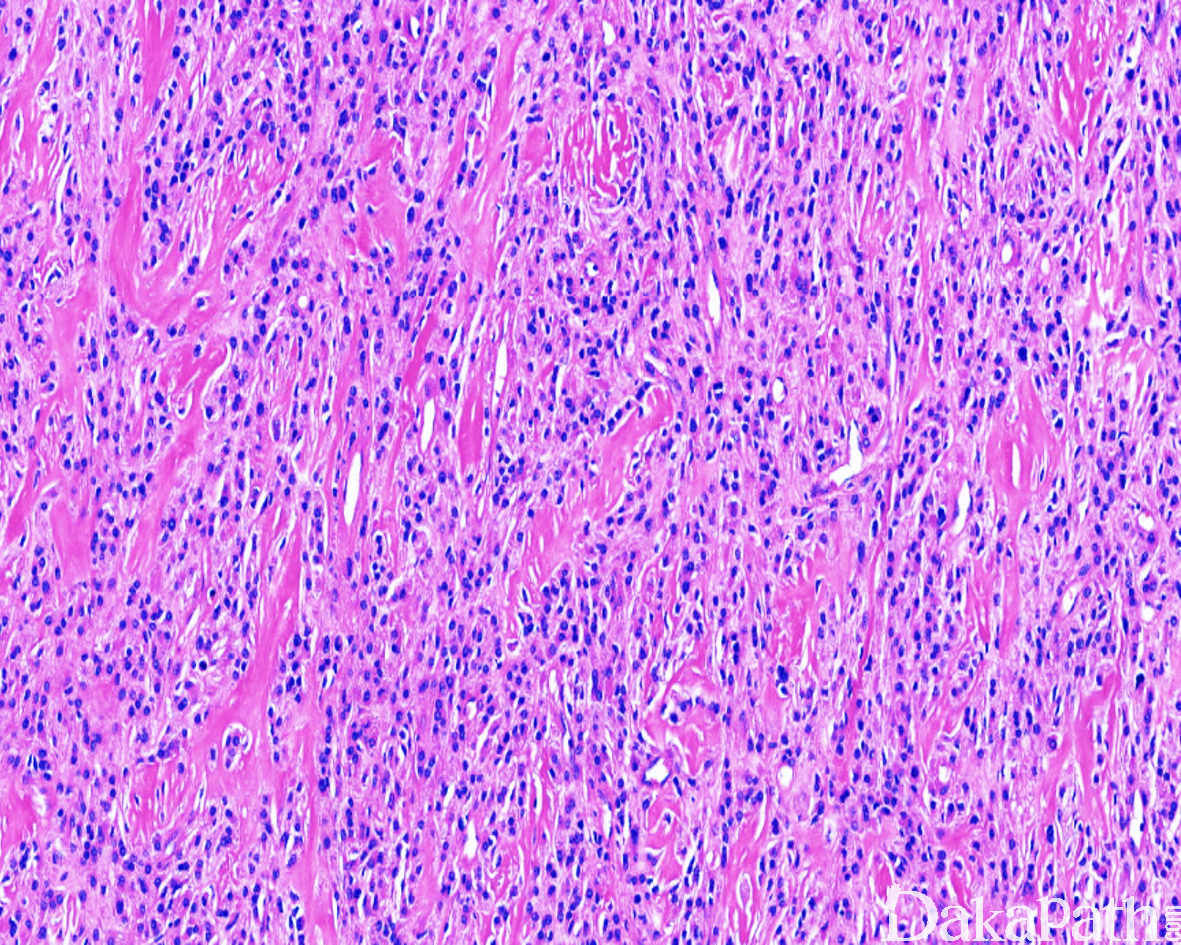

软组织骨化性纤维黏液样肿瘤
Ossifing Fibromyxoid tumor of soft Tissue,OFMT
发病部位: 四肢的近端、头颈部和躯干,少数位于手、足、纵隔或腹膜后
诊断要点:
- 主要发生于中老年,男/女约 1.5-2:1,好发于四肢的近端、头颈部和躯干,常表现为缓慢性生长的皮下孤立性结节,少数位于肌肉内;
- 肿瘤直径通常< 4cm, 大体检查肿瘤呈卵圆形结节状或分叶状,多数有纤维性包膜,典型病例包膜内含有一层薄层的不完整性蛋壳样骨壳, 切面实性伴有粘稠感;恶性转化的肿瘤可突破骨壳向周围组织浸润性生长;
- 镜下 80%左右的病例可见骨壳,骨壳由不连续的化生性板层骨组成,小梁周围的骨母细胞缺如或小而不明显,骨小梁可向内深入肿瘤实质内;极个别病例中,骨组织位于肿瘤的中央;
- 肿瘤的实质由多个大小不一、细胞密度不均的小叶组成,小叶内的瘤细胞呈交织索状、梁状、短束状、纤细的网格状排列,有时也可呈马赛克样排列;小叶间为粗细不等的纤维性间隔;
- 细胞圆形、卵圆形或短梭形,大小较一致,胞质淡染或呈嗜伊红色,核染色质细致,核分裂像一般较少见(<2/50HPF),无非典型核分裂象,罕见坏死;
- 瘤细胞间的基质多呈纤维黏液样,或伴多少不等的胶原纤维,部分区域显示明显的玻璃样变性,似骨样基质;
- 部分病例骨壳不明显或仅为局灶性,少数病例包膜内缺乏骨壳结构,可称为“非骨化性纤维黏液样肿瘤”;
- 恶性骨化性纤维黏液样肿瘤的定义标准尚不清楚,瘤细胞密度增高伴弥漫的细胞异型性,核分裂像>2/1 0HPF 者,可称为“非典型性或恶性骨化性纤维黏液样肿瘤”。

免疫组织化学染色:
肿瘤细胞 vimentin、S-100. CD10 和 NSE 阳性,部分病例 Leu7. desmin 和 GFAP 阳性,INI-1 显示马赛克样的表达缺失,SOX10 阴性。
分子标记:
PHF1 基因重排
鉴别诊断:
- 神经鞘瘤 :无化生性骨壳,可见典型的 Antoni A 区和 Antoni B 区交替分布。
- 神经鞘黏液瘤 :多位于浅表真皮内,无化生性骨壳。
- 软组织骨肉瘤 :肿瘤内能见到肯定的肿瘤性骨样组织,但无骨壳样结构,瘤细胞丰富且异型性明显,核分裂像常见。
预后:
普通的骨化性纤维黏液样肿瘤的生物学进程表现为惰性,完整切除罕见复发和转移;核分裂象> 2/10HPF 者复发率增高;瘤细胞密度高伴有明显的细胞异型性和核分裂象者,复发和转移率更高。
治疗:
局部扩大切除
参考文献:
Folpe AL, Weiss SW. Ossifying fibromyxoid tumor of soft parts: a clinicopathologic study of 70 cases with emphasis on atypical and malignant variants. Am J Surg Pathol 2003;27:421–31. Miettinen M, Finnell V, Fetsch JF. Ossifying fibromyxoid tumor of soft parts–a clinicopathologic and immunohistochemical study of 104 cases with long-term follow-up and a critical review of the literature. Am J Surg Pathol 2008;32:996–1005. Graham RP, Dry S, Li X, et al. Ossifying fibromyxoid tumor of soft parts: a clinicopathologic, proteomic, and genomic study. Am J Surg Pathol 2011;35: 1615–25.
← 上皮样肉瘤 SMARCA4缺陷型胸腔肉瘤 →
